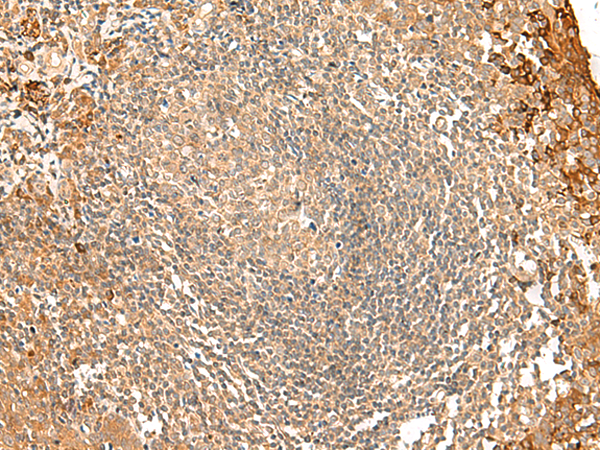
一抗

|
Background: |
The protein encoded by this gene binds to both CDC42 and N-WASP. This protein promotes CDC42-induced actin polymerization by activating the N-WASP-WIP complex and, therefore, is involved in a pathway that links cell surface signals to the actin cytoskeleton. Alternative splicing results in multiple transcript variants encoding different isoforms. |
|
Applications: |
ELISA, IHC |
|
Name of antibody: |
FNBP1L |
|
Immunogen: |
Synthetic peptide of human FNBP1L |
|
Full name: |
formin binding protein 1 like |
|
Synonyms: |
TOCA1; C1orf39 |
|
SwissProt: |
Q5T0N5 |
|
ELISA Recommended dilution: |
5000-10000 |
|
IHC positive control: |
Human tonsil |
|
IHC Recommend dilution: |
40-200 |

 購物車
購物車 幫助
幫助
 021-54845833/15800441009
021-54845833/15800441009